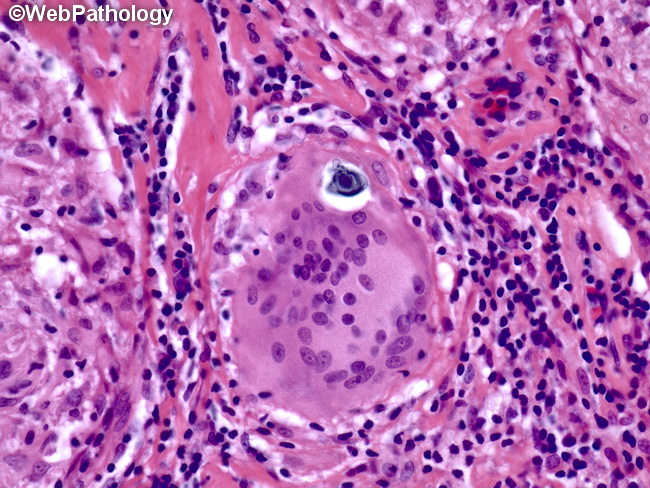

Classic presentation
- HiIar lymphadenopathy
- Cough, dyspnea
- Often asymptomatic, detected on routine chest x-ray
Etiology
Pathophysiology
Sarcoidosis is a systemic disorder characterized by widespread, immune-mediated formation of noncaseating granulomas.
- General
- Inhalation of foreign antigen → monocyte differentiation → activation of interstitial dendritic cells and alveolar macrophages
- Interstitial dendritic cells migrate towards mediastinal lymph nodes and alveolar macrophages differentiate, serving as antigen-presenting cells to circulating T helper (Th) cells → differentiation and clonal expansion of T cells
- T cell recruitment and ↑ B-cell activity → local immune hyperactivity and inflammation → formation of noncaseating granulomas in the lungs and the lymphatic system
- Granuloma formation: Mature granulomas are composed of epithelioid cells and macrophages surrounded by lymphocytes and fibroblasts.
- Macrophages activate Th1 cells.
- Th1 cells stimulate the formation of epithelioid cells and multinucleated giant cells by releasing IFN-γ.

- Epithelioid cells produce angiotensin-converting enzyme (ACE) and release cytokines that recruit more immune cells.
- Asteroid bodies: star-shaped, eosinophilic inclusion bodies consisting of various lipids (e.g., from sarcoidosis, foreign body reactions)

Tip
Compared with TB, which has caseating granulomas.
- Fibrosis: Epithelioid cells secrete cytokines to recruit fibroblasts, leading to fibrosis → damage of organs and tissue
- Calcium dysregulation: activated pulmonary alveolar macrophages → ↑ 1-alpha hydroxylase expression and activity → ↑ 1,25-dihydroxyvitamin D (calcitriol) → hypervitaminosis D → hyperphosphatemia, hypercalcemia, and, possibly, renal failure
Clinical features
Pulmonary sarcoidosis
- Lungs are the most commonly affected organ (90% of affected individuals).
- Often asymptomatic in the early stages
- Classic finding is hilar lymphadenopathy

- Interstitial fibrosis
- Cough, exertional dyspnea, chest pain
- Mild rales on pulmonary auscultation
Extrapulmonary sarcoidosis
Cutaneous sarcoidosis
- Erythema nodosum: most common nonspecific cutaneous manifestation

- Lupus pernio
- A pathognomonic manifestation of sarcoidosis characterized by extensive, violaceous skin plaques (i.e., epithelioid granulomas of the dermis) on the nose, cheeks, chin, and/or ears
Butterfly rash as seen in systemic lupus erythematosus
Neurosarcoidosis
- Cranial nerve palsy (unilateral or bilateral facial nerve palsy is the most common)
- Diabetes insipidus
Ocular sarcoidosis
- Sarcoid uveitis
- Most common ocular manifestation
- Manifests with pain, redness, and photophobia
Cardiac sarcoidosis
- AV block, arrhythmias, restrictive cardiomyopathy. c
Symptoms of hypercalcemiaClinical features
- Nephrolithiasis, nephrocalcinosis (calcium oxalate > calcium phosphate stones)
- Bone pain, arthralgias, myalgias, fractures
- Because most of the calcium is released from bones
- Constipation
- Increase in extracellular Ca2+ → membrane potential outside is more positive → more amount of depolarization is needed to initiate action potential → decreased excitability of muscle and nerve tissue
- Abdominal pain
- Nausea and vomiting
- Anorexia
- Peptic ulcer disease
- hypercalcemia-induced increase of gastric acid secretion and gastrin levels.
- Neuropsychiatric symptoms such as anxiety, depression, fatigue, and cognitive dysfunction
- Diminished muscle excitability
- Cardiac arrhythmias
- ECG: Shorten QT interval, see QT interval
- Muscle weakness, paresis
- Polyuria and dehydration c
- Due to acquired renal ADH resistance. Although ADH is being secreted, the kidneys no longer respond to it adequately (nephrogenic diabetes insipidus).
- Physiological teleology: Stone Prevention: If the kidney concentrated urine in the setting of hypercalciuria (high urinary Ca), the calcium would precipitate into stones (nephrolithiasis)

Link to original
Clinical features
- Nephrolithiasis, nephrocalcinosis (calcium oxalate > calcium phosphate stones)
- Bone pain, arthralgias, myalgias, fractures
- Because most of the calcium is released from bones
- Constipation
- Increase in extracellular Ca2+ → membrane potential outside is more positive → more amount of depolarization is needed to initiate action potential → decreased excitability of muscle and nerve tissue
- Abdominal pain
- Nausea and vomiting
- Anorexia
- Peptic ulcer disease
- hypercalcemia-induced increase of gastric acid secretion and gastrin levels.
- Neuropsychiatric symptoms such as anxiety, depression, fatigue, and cognitive dysfunction
- Diminished muscle excitability
- Cardiac arrhythmias
- ECG: Shorten QT interval, see QT interval
- Muscle weakness, paresis
- Cardiac arrhythmias
- Polyuria and dehydration c
- Due to acquired renal ADH resistance. Although ADH is being secreted, the kidneys no longer respond to it adequately (nephrogenic diabetes insipidus).
- Physiological teleology: Stone Prevention: If the kidney concentrated urine in the setting of hypercalciuria (high urinary Ca), the calcium would precipitate into stones (nephrolithiasis)

Link to original
Diagnostics
Tip
Increased ACE levels may be seen. However, they are not specific for sarcoidosis and should not be used in isolation for diagnosis or monitoring.
- Initial: CXR showing Bilateral Hilar Lymphadenopathy (BHL) +/- interstitial infiltrates.


- Key Labs:
- Hypercalcemia/Hypercalciuria: Due to ↑ 1-alpha hydroxylase activity in sarcoid macrophages (↑ 1,25-dihydroxyvitamin D).
- ↑ ACE levels (high sensitivity, low specificity; used to monitor disease activity).
- PFTs: Restrictive pattern (↓ FVC, ↓ TLC, ↓ DLCO). c
- Confirmatory/Gold Standard: Tissue biopsy showing Non-caseating granulomas.
- Must rule out TB (AFB stain) and Fungal (GMS/Silver stain).
- Biopsy most accessible site (e.g., palpable node, skin lesion). If only BHL, use Transbronchial Biopsy (TBBx).
- Schaumann bodies: cellular inclusion bodies consisting of intracytoplasmic calcium and protein with laminar stratification (e.g., sarcoidosis, tuberculosis, Crohn disease, berylliosis)
Additional studies
- Bronchoalveolar lavage (BAL):↑ CD4:CD8 ratio
- CD4+ lymphocytes release interferon-gamma and TNF-alpha to drive macrophage activation and granuloma formation.
Treatment
- Steroids
- Other immunosuppressants
